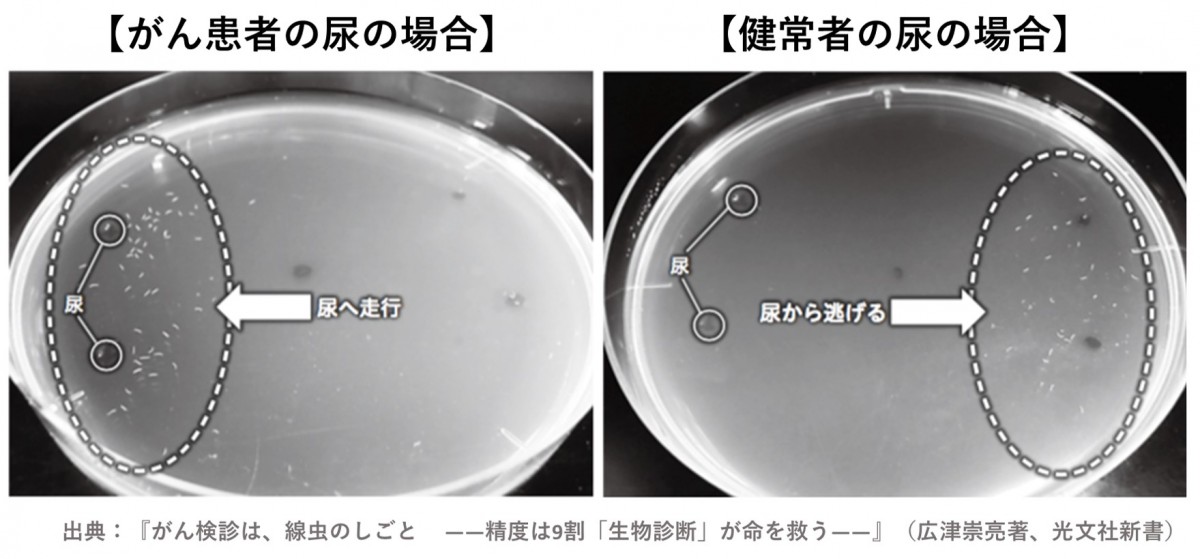
日本 檢驗 癌症 一滴尿

【癌症】日本研一滴尿驗15種癌,800港元有找擬明年推出!
之前有一滴血能測多種癌症,如今有一滴尿就能檢測癌症的方法,而且要價800港元有找!日本企業廣津生物科學公司HIROTSUバイオサイエンス近日宣布研發出一種利用一滴尿液即可驗出是否患癌的方法,準確率高達85%,預計2020年1月可以正式推出。

根據日媒報道,這種測試方法是透過一種名為線蟲的寄生蟲,其靈敏的嗅覺分辨出罹癌者的尿液,可以驗出如大腸癌、乳癌、胃癌等15種癌症。這種寄生蟲主要生活在土壤中,沒有眼睛與耳朵,但其嗅覺卻非常靈敏,約有1200種嗅覺基因,比人類的400種以及狗的800種還要多。
線蟲會被罹癌者的尿液吸引,因為罹癌者的尿液中會散發出特殊的味道,該味道與牠們的食物-大腸桿菌群的味道相似,所以牠們會聚集在罹癌者的尿液四周,遇到健康的尿液則會遠離。
Photo from moneyforward
Photo from moneyforward
不過線蟲無法直接判定罹癌者到底是罹患哪一種癌症,因此還必須再搭配進一步的檢查。不過「線蟲之鼻」可以讓患者及早發現並及早治療癌症,也不會有侵入性問題,準確率高達85%,要價則只需一萬日圓(約711港元),減低了篩檢所需的昂貴成本,技術預計在明年一月正式推出。
Text by BusinessFocus Editorial







